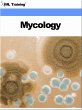
Mycology (Microbiology and Blood)... - Bild 1

Mycology (Microbiology and Blood) (eBook, ePUB)

PAYBACK Punkte
0 °P sammeln!
MycologyIn recent years there has been an increasing incidence of mycoses and diseases caused by fungi. This increase is largely due to the widespread use of antibiotic, immunosuppressive, corticosteroid, and cytotoxic drugs. Because of this increased incidence of mycoses, a need for laboratory specialists to learn about and to identify medically important fungi is greater than ever.This course discusses important topics such as procedures for the collection and processing of mycologic specimens, media and equipment, taxonomy and characteristics of important fungi, and techniques for the cultu...
Mycology
In recent years there has been an increasing incidence of mycoses and diseases caused by fungi. This increase is largely due to the widespread use of antibiotic, immunosuppressive, corticosteroid, and cytotoxic drugs. Because of this increased incidence of mycoses, a need for laboratory specialists to learn about and to identify medically important fungi is greater than ever.
This course discusses important topics such as procedures for the collection and processing of mycologic specimens, media and equipment, taxonomy and characteristics of important fungi, and techniques for the culture and identification of fungal pathogens.
This course is part of our Microbiology and Blood series.
Includes a questions and answers section at the end of each lesson.
Full illustrations and diagrams included.
Lessons:
- Introduction to Medical Mycology
- Collection and Processing Procedures for Mycological Studies
- Saprophytic Fungi
- Yeasts of Medical Importance
- Cutaneous Fungi
- Subcutaneous Fungi
- Systemic Mycoses
- Mycological Procedures
- Media and Reagents
- Maintaining Stock Cultures
- Commercial Kits
In recent years there has been an increasing incidence of mycoses and diseases caused by fungi. This increase is largely due to the widespread use of antibiotic, immunosuppressive, corticosteroid, and cytotoxic drugs. Because of this increased incidence of mycoses, a need for laboratory specialists to learn about and to identify medically important fungi is greater than ever.
This course discusses important topics such as procedures for the collection and processing of mycologic specimens, media and equipment, taxonomy and characteristics of important fungi, and techniques for the culture and identification of fungal pathogens.
This course is part of our Microbiology and Blood series.
Includes a questions and answers section at the end of each lesson.
Full illustrations and diagrams included.
Lessons:
- Introduction to Medical Mycology
- Collection and Processing Procedures for Mycological Studies
- Saprophytic Fungi
- Yeasts of Medical Importance
- Cutaneous Fungi
- Subcutaneous Fungi
- Systemic Mycoses
- Mycological Procedures
- Media and Reagents
- Maintaining Stock Cultures
- Commercial Kits
Dieser Download kann aus rechtlichen Gründen nur mit Rechnungsadresse in A, B, CY, CZ, D, DK, EW, E, FIN, F, GR, H, IRL, I, LT, L, LR, M, NL, PL, P, R, S, SLO, SK ausgeliefert werden.